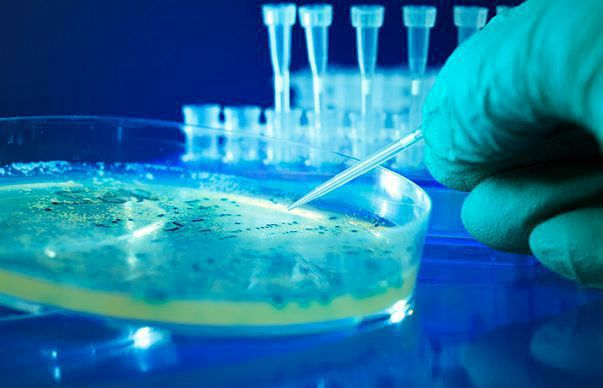
ALARMANT | Hepatita C face ravagii în România

România are cea mai ridicată rată a prevalenţei infecţiei cu virusul hepatitei C din Uniunea Europeană - 3,3 la sută, estimându-se că peste 650.000 de persoane ar fi infectate cu acest virus, a declarat managerul Institutului Naţional de Boli Infecţioase "Matei Balş", prof. Adrian Streinu-Cercel.
Specialistul a adăugat că 99 la sută dintre infecţii aparţin genotipului 1b, acestea fiind asociate cu risc mai crescut de apariţie a cirozei hepatice, iar peste 550.000 de persoane ar avea boală activă, progresivă. "România se aliniază recomandărilor OMS privind controlul infecţiei cu virusul hepatitei C. În 2017, în România a crescut atât numărul persoanelor diagnosticate, cât şi accesul la terapiile cu medicamente anti-virale cu acţiune directă", a precizat Streinu-Cercel, potrivit Agerpres.
În România, pentru 2018, direcţiile de acţiune recomandate vizează extinderea testării populaţiei şi asigurarea accesului larg la terapii antivirale eficiente. La rândul său, ministrul Sănătăţii, Sorina Pintea, a susţinut că este pentru prima dată când medicii de familie pot să recomande în cadrul pachetului de bază recoltarea antigenilor HBs şi a anticorpilor HCV tuturor pacienţilor.
Organizaţia Mondială a Sănătăţii estimează că 71 milioane de persoane sunt infectate, în prezent, cu virusul hepatitic C la nivel mondial.